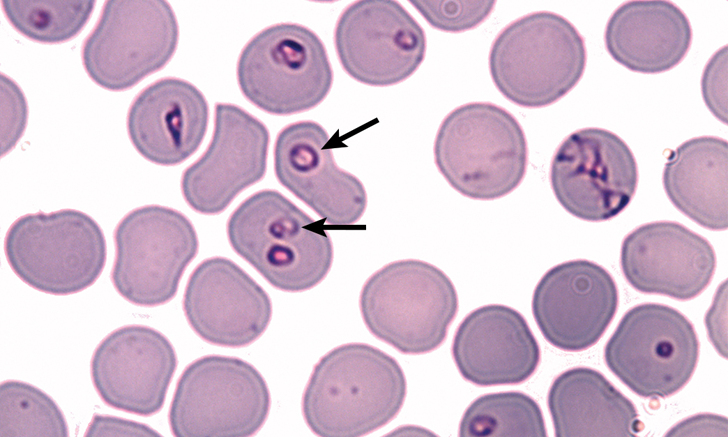

Dog blood parasite treatment sales
Dog blood parasite treatment sales, Pet Care for Dogs Monster Pet Vet sales
$78.00
SAVE 50% OFF
$39.00
$0 today, followed by 3 monthly payments of $13.00, interest free. Read More
Dog blood parasite treatment sales
Pet Care for Dogs Monster Pet Vet
Biliary in Dogs Bosa Medical Health
BLOOD PARASITE IN Pawventures Veterinary Clinic Bulaon
Beware It s been tick season and PAWSsion Project Facebook
Top 5 Transplacental Parasitic Infections in Dogs
Vaccinations anti parasite treatment etc. Perfect Pedigree Thailand
Description
Product code: Dog blood parasite treatment sales
Parasites in Dogs You Should Know sales, Pet Care for Dogs Monster Pet Vet sales, Biliary in Dogs Bosa Medical Health sales, BLOOD PARASITE IN Pawventures Veterinary Clinic Bulaon sales, Beware It s been tick season and PAWSsion Project Facebook sales, Top 5 Transplacental Parasitic Infections in Dogs sales, Vaccinations anti parasite treatment etc. Perfect Pedigree Thailand sales, Parasites Heartworms Animal Hospital Southwest sales, Hookworms in Dogs PetMD sales, Why Prevention of Heartworm Disease is the Best Treatment sales, Warning Rising cases of blood parasites Symptoms and cause sales, Canine Babesiosis Protect Your Dog from Parasite Carrying Ticks sales, Isulan Animal Clinic Another patient with BLOOD PARASITISM. Kobe sales, Ehrlichiosis in dogs Ehrlichia canis Agriculture and Food sales, Common Parasites in Dogs sales, Parasitic Blood Infection Haemobartonellosis sales, Parasites In Dogs Types Symptoms Treatment Prevention More sales, Ehrlichiosis in Dogs sales, Veterinary Sciences Free Full Text Parasite Specific Antibody sales, PetLandia Vets Malolos sales, How To Get Rid Of Worms In Dogs Dutch sales, Parasite Testing and Prevention Wilbraham Animal Hospital sales, Blood Parasites in Dogs Rural versus Urban Considerations sales, Parasitic Blood Infection Haemobartonellosis in Dogs Symptoms sales, GAMOT SA BLOOD PARASITE NG ASO DAHON LANG.MABISA AT EPEKTIBO LIBRE sales, Common blood parasites in dogs PPT sales, Ticks of Dogs Dog Owners Merck Veterinary Manual sales, Beware It s been tick season and PAWSsion Project Facebook sales, Hepatozoonosis an overview ScienceDirect Topics sales, Intestinal Parasites Dupont Veterinary Clinic sales, Parasitic Blood Infection Haemobartonellosis in Dogs PetMD sales, Puppy Parasites Preventing Diagnosing and Treating Parasites in sales, How To Give Your Dog A Parasite Cleanse sales, We Aren t Just Rescuing Dogs Hillcrest Animal Hospital sales, Babesiosis Wikipedia sales, Hot Spots on Dogs Small Door Veterinary sales, Common blood parasites in dogs PPT sales, Blood Parasites in Dogs Types Symptoms Treatment Canine sales, Worms in Dogs 4 Most Common Gold Coast Parasites Symptoms sales, Babesia negevi n. sp. type material in stained blood smears from a sales, Treatment of Ehrlichiosis in Dogs Flat Rock Emergency Vet sales, Parasitic Blood Infection Haemobartonellosis in Dogs Symptoms sales, Macrocyclic lactone resistance in Dirofilaria immitis risks for sales, Thin blood smear of a dog from Slovenia infected with B. canis sales, Treating Parasites In Dogs Heartworm Hookworm and Tapeworm sales, Signs and Symptoms of Parasites in Dogs Nom Nom sales, 10 Causes of Blood in Dog Poop and Common Treatments PetHelpful sales, Biliary in dogs understanding tickbite fever symptoms of sales, Common blood parasites in dogs PPT sales, Parasites Animal Humane Society sales.
Parasites in Dogs You Should Know sales, Pet Care for Dogs Monster Pet Vet sales, Biliary in Dogs Bosa Medical Health sales, BLOOD PARASITE IN Pawventures Veterinary Clinic Bulaon sales, Beware It s been tick season and PAWSsion Project Facebook sales, Top 5 Transplacental Parasitic Infections in Dogs sales, Vaccinations anti parasite treatment etc. Perfect Pedigree Thailand sales, Parasites Heartworms Animal Hospital Southwest sales, Hookworms in Dogs PetMD sales, Why Prevention of Heartworm Disease is the Best Treatment sales, Warning Rising cases of blood parasites Symptoms and cause sales, Canine Babesiosis Protect Your Dog from Parasite Carrying Ticks sales, Isulan Animal Clinic Another patient with BLOOD PARASITISM. Kobe sales, Ehrlichiosis in dogs Ehrlichia canis Agriculture and Food sales, Common Parasites in Dogs sales, Parasitic Blood Infection Haemobartonellosis sales, Parasites In Dogs Types Symptoms Treatment Prevention More sales, Ehrlichiosis in Dogs sales, Veterinary Sciences Free Full Text Parasite Specific Antibody sales, PetLandia Vets Malolos sales, How To Get Rid Of Worms In Dogs Dutch sales, Parasite Testing and Prevention Wilbraham Animal Hospital sales, Blood Parasites in Dogs Rural versus Urban Considerations sales, Parasitic Blood Infection Haemobartonellosis in Dogs Symptoms sales, GAMOT SA BLOOD PARASITE NG ASO DAHON LANG.MABISA AT EPEKTIBO LIBRE sales, Common blood parasites in dogs PPT sales, Ticks of Dogs Dog Owners Merck Veterinary Manual sales, Beware It s been tick season and PAWSsion Project Facebook sales, Hepatozoonosis an overview ScienceDirect Topics sales, Intestinal Parasites Dupont Veterinary Clinic sales, Parasitic Blood Infection Haemobartonellosis in Dogs PetMD sales, Puppy Parasites Preventing Diagnosing and Treating Parasites in sales, How To Give Your Dog A Parasite Cleanse sales, We Aren t Just Rescuing Dogs Hillcrest Animal Hospital sales, Babesiosis Wikipedia sales, Hot Spots on Dogs Small Door Veterinary sales, Common blood parasites in dogs PPT sales, Blood Parasites in Dogs Types Symptoms Treatment Canine sales, Worms in Dogs 4 Most Common Gold Coast Parasites Symptoms sales, Babesia negevi n. sp. type material in stained blood smears from a sales, Treatment of Ehrlichiosis in Dogs Flat Rock Emergency Vet sales, Parasitic Blood Infection Haemobartonellosis in Dogs Symptoms sales, Macrocyclic lactone resistance in Dirofilaria immitis risks for sales, Thin blood smear of a dog from Slovenia infected with B. canis sales, Treating Parasites In Dogs Heartworm Hookworm and Tapeworm sales, Signs and Symptoms of Parasites in Dogs Nom Nom sales, 10 Causes of Blood in Dog Poop and Common Treatments PetHelpful sales, Biliary in dogs understanding tickbite fever symptoms of sales, Common blood parasites in dogs PPT sales, Parasites Animal Humane Society sales.